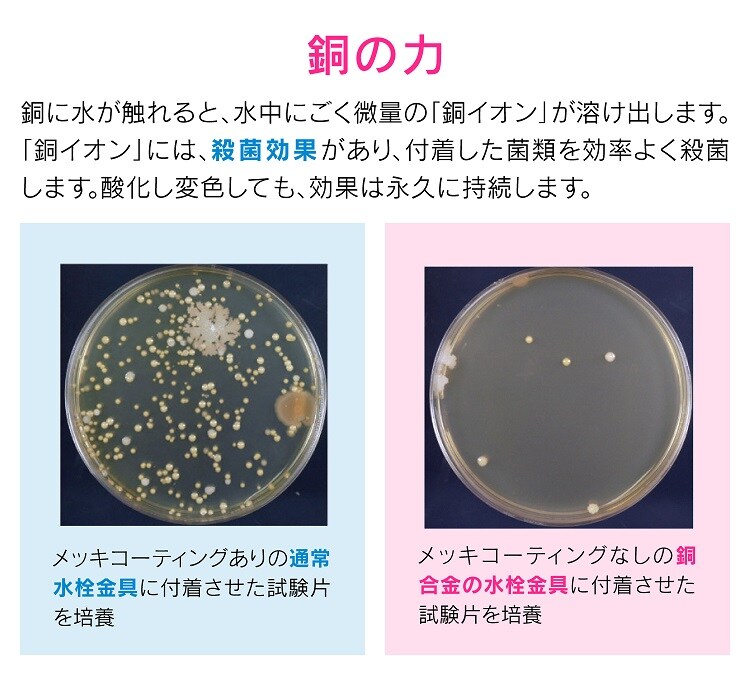

5/9
時点_ポイント最大21倍
カクダイ GAONA(ガオナ) これカモ ゴミこし 銅製 GA-MG007 (1個)
販売価格
1,065
円 (税込)
- 出荷目安:
- 取り寄せ商品(通常1週間-10日)
たまるdポイント(通常) 9
+キャンペーンポイント(期間・用途限定) 最大20倍
※たまるdポイントはポイント支払を除く商品代金(税抜)の1%です。
※表示倍率は各キャンペーンの適用条件を全て満たした場合の最大倍率です。
各キャンペーンの適用状況によっては、ポイントの進呈数・付与倍率が最大倍率より少なくなる場合がございます。
dカードでお支払ならポイント3倍
各キャンペーンの適用状況によっては、ポイントの進呈数・付与倍率が最大倍率より少なくなる場合がございます。
- 商品情報
- レビュー
【ブランド】
GAONA
【発売元、製造元、輸入元又は販売元】
カクダイ
商品に関するお電話でのお問合せは、下記までお願いいたします。
カクダイ:06-6538-1121
GAONA:03-3552-0981
リニューアルに伴い、パッケージ・内容等予告なく変更する場合がございます。予めご了承ください。


【カクダイ GAONA(ガオナ) これカモ ゴミこし 銅製 GA-MG007の商品詳細】
●小物の流失や排水パイプの詰まりを予防する洗面・手洗器用のゴミ受け。
●洗面・手洗器の排水口に取付けるだけで、小物の流失や排水パイプのつまりを防ぎます。
●メッシュ状のアミが細かいゴミも逃さずキャッチします。
●銅イオンの殺菌効果でヌメリやにおいを防ぎます(使用を重ねるうちに黒ずんでいき、次第に薄青みがかった皮膜に変色しますが、銅イオンの殺菌効果は変わりませんので安心してお使いください)。
●排水口径30~38ミリの洗面・手洗器に使用できます。
【原材料】
【規格概要】
【注意事項】
強酸性の洗浄剤、薬品、油、熱湯などは流さないでください。器具破損の恐れがあります。
GAONA
【発売元、製造元、輸入元又は販売元】
カクダイ
商品に関するお電話でのお問合せは、下記までお願いいたします。
カクダイ:06-6538-1121
GAONA:03-3552-0981
リニューアルに伴い、パッケージ・内容等予告なく変更する場合がございます。予めご了承ください。

【カクダイ GAONA(ガオナ) これカモ ゴミこし 銅製 GA-MG007の商品詳細】
●小物の流失や排水パイプの詰まりを予防する洗面・手洗器用のゴミ受け。
●洗面・手洗器の排水口に取付けるだけで、小物の流失や排水パイプのつまりを防ぎます。
●メッシュ状のアミが細かいゴミも逃さずキャッチします。
●銅イオンの殺菌効果でヌメリやにおいを防ぎます(使用を重ねるうちに黒ずんでいき、次第に薄青みがかった皮膜に変色しますが、銅イオンの殺菌効果は変わりませんので安心してお使いください)。
●排水口径30~38ミリの洗面・手洗器に使用できます。
【原材料】
| 銅 |
【規格概要】
| ・取付可能排水口径:30~38mm |
【注意事項】
強酸性の洗浄剤、薬品、油、熱湯などは流さないでください。器具破損の恐れがあります。







